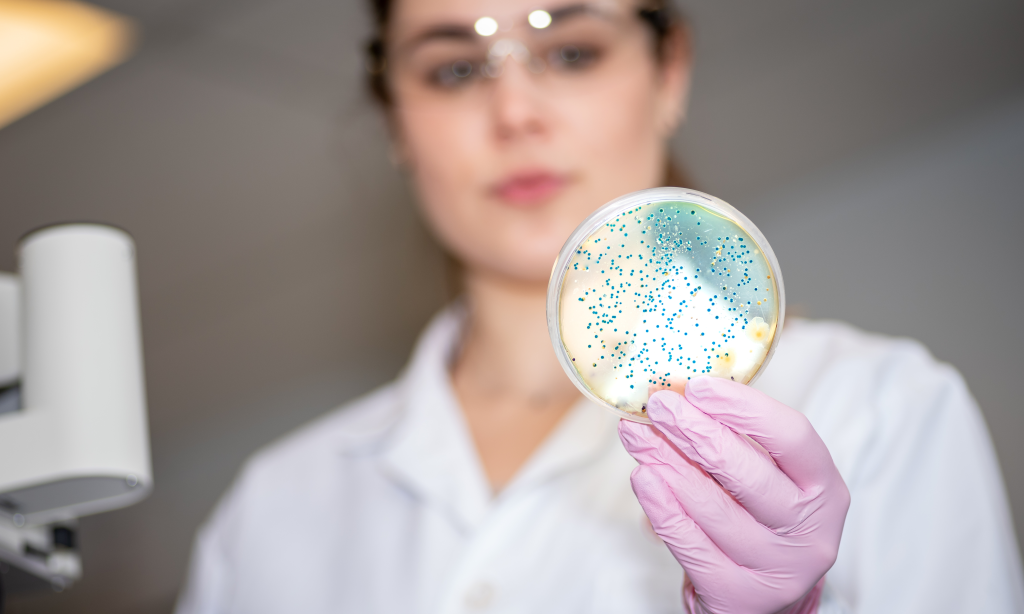

Diensten

Orthomoleculaire therapie
Orthomoleculaire therapie is onderdeel van de natuurgeneeskunde en is gebaseerd op het evolutionair denken waarbij het lichaam een goede levensstijl herkent.
Het doel is om een optimale concentratie voedingsstoffen in iemands lichaam te realiseren.
Orthomoleculaire therapie leidt tot het verhelpen van lichamelijke en geestelijke klachten en speelt zeker een belangrijk rol bij de preventie van veelvoorkomende ziektebeelden.

🩸 Nieuw: Bloedanalyse
In samenwerking met artsen bieden wij nu bloedanalyses aan. Op basis van jouw bloedwaarden krijg je een persoonlijke interpretatie en concrete adviezen rond voeding, supplementen en levensstijl. Zo brengen we eventuele tekorten of onevenwichten in kaart en ondersteunen we jouw lichaam om optimaal te functioneren.
Testen
Meten is weten.
Afhankelijk van de klachten kunnen verschillende testen gehanteerd worden. Dit wordt tijdens de consulten besproken.
mogelijke testen:
- Suikeranalyse
- DNA-Analyse
- Lichaamsanalyse
- Microbioom test
- Stress-test
- Intolerantie test
Klachten.
Voor volgende klachten kan je bij mij terecht:
- Vermoeidheid
- Darmklachten
- Prikkelbare darm
- Intoleranties
- Overgewicht
- Hoofdpijn/Migraine
- Zwak immuunsysteem
- Insuline resistentie/ Pre-diabetes
- . . .



